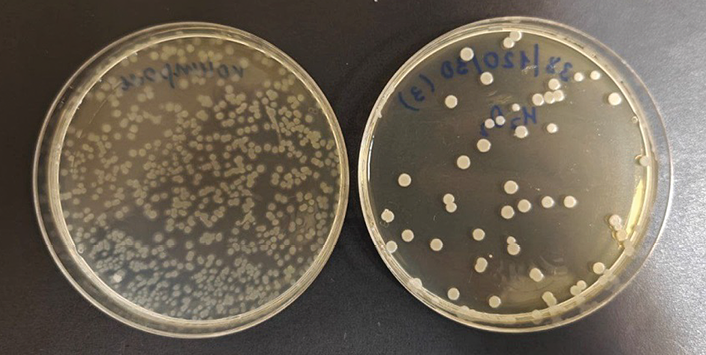
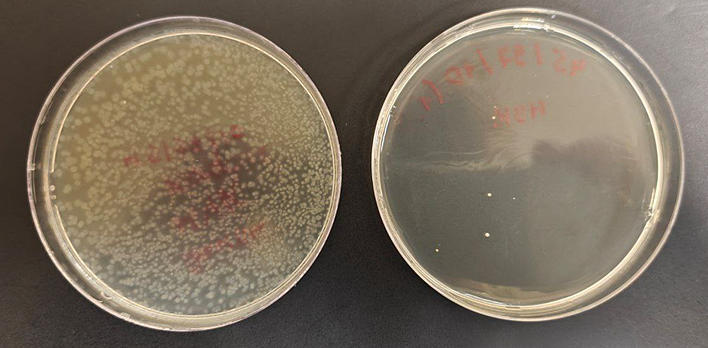

Scroll to:
Optimization and validation of Bacillus subtilis spore inactivation regimes in supercritical carbon dioxide: Pure gas, hydrogen peroxide, peracetic acid
https://doi.org/10.47183/mes.2025-359
Abstract
Introduction. Healthcare-associated infections (HAIs) continue to pose a significant challenge to public health. The existing sterilization methods possess a number of limitations regarding their applicability to heat-sensitive materials and the possibility of residual toxicity or material damage. Sterilization using supercritical carbon dioxide, particularly in combination with oxidative additives, appears to be a promising alternative capable of providing the required level of microbial safety at low temperatures and moderate pressures. However, the available data show significant variability depending on experimental conditions, indicating the need for optimization and validation of processing regimes.
Objective. Optimization and validation of Bacillus subtilis spore sterilization regimes in an experiment using supercritical carbon dioxide (scCO2), including pure scCO2, scCO2 with hydrogen peroxide (H2O2), and scCO2 with peracetic acid (PAA).
Materials and methods. Experiments were conducted using a prototype test bench for investigating sterilization regimes. Bacillus subtilis subsp. spizizenii ATCC 6633 NCTC 10400 was used as the biological indicator. The study involved the contamination of titanium discs with spores followed by their treatment under the three regimes (pure scCO2, scCO2 + H2O2, scCO2 + PAA). Further, microbiological analysis with enumeration of surviving spores and statistical processing of the results were carried out. For each regime, central composite experimental designs were implemented, varying temperature, pressure, and exposure duration. Efficacy was assessed based on the log-reduction of viable spores. Validation series included 10 independent replicates each.
Results. Gas-dynamic treatment with pure scCO2 in the range of 35–60°C, 70–120 atm, and 60–120 min proved ineffective (maximum log-reduction ≤ 0.8). The addition of oxidizing agents significantly increased the degree of inactivation: for the scCO2 + H2O2 (200 ppm) regime, the optimal parameters were 37.9°C, 120 atm, 30 min (log-reduction 4.4 ± 0.3; CV = 7.3%); for scCO2 + PAA (50 ppm) — 45°C, 94 atm, 10 min (log-reduction 6.0 ± 0.3; CV = 4.9%), which meets the requirements for the sterility assurance level (SAL) for medical devices. The PAA regime provided a statistically significant higher efficacy compared to H2O2 (t-test, p < 0.001).
Conclusions. The sterilization methodology based on supercritical carbon dioxide with the addition of hydrogen peroxide or peracetic acid ensures effective inactivation of Bacillus subtilis spores under parameters compatible with the low-temperature processing of heat-sensitive medical materials, thus meeting modern sterility requirements for medical devices.
Keywords
For citations:
Gvetadze R.Sh., Galstyan M.S., Kharakh Ya.N., Kolesnikov P.Yu., Kirakosyan L.G., Podporin M.S., Tsarev V.N., Arutyunov S.D. Optimization and validation of Bacillus subtilis spore inactivation regimes in supercritical carbon dioxide: Pure gas, hydrogen peroxide, peracetic acid. Extreme Medicine. 2026;28(1):134-145. https://doi.org/10.47183/mes.2025-359
INTRODUCTION
Healthcare-associated infections (HAIs) continue to pose a significant challenge to public health. According to a number of publications, the surfaces of medical devices can facilitate the formation of biofilms and the spread of resistant pathogens, complicating the prevention and treatment of HAIs [1–3]. Several studies have noted the role of tightening requirements for device safety and biocompatibility in the adoption of new materials and more complex designs, which may limit the applicability of some conventional sterilization methods due to potential risks of degradation or residual toxicity [2][4]. Well-established sterilization methods, such as autoclaving, radiation, and gas treatment (e.g., with ethylene oxide), have limited applicability to heat-sensitive materials due to the possibility of residual toxicity or structural alterations in devices [4]. In this context, sterilization using supercritical carbon dioxide (scCO2) is considered a promising alternative as a method integrating efficacy, safety, and compatibility with modern materials.
In order to reduce the risk of device contamination, the inactivation of both vegetative and spore-forming bacteria should be ensured. Among spore-forming species, Bacillus subtilis is widely used as a model test organism in sterilization studies [5–7]. Given the increasing constraints on materials and device designs, there is a growing interest in novel low-temperature methods that exhibit effectiveness while preserving the functional properties of materials. Spore-forming bacilli, particularly B. subtilis and B. stearothermophilus, are known to be among the most resistant microorganisms to eradication due to the protective structural features of their spores, making them benchmark indicators of sterilization efficacy [5][7].
A number of experimental studies have demonstrated that the use of scCO2, as well as its combinations with various oxidizing agents, can effectively inactivate B. subtilis spores under different processing parameters [5–9]. The authors of most publications emphasize that the proposed sterilization regimes cannot be considered a versatile solution; moreover, the existing data show a significant variability in effectiveness depending on experimental conditions and protocols used [5–7][10]. Therefore, in our study, the ranges of parameters are selected following a review of literature data and considering the engineering constraints of our laboratory facility (maximum pressure 120 atm).
In this work, we aim to optimize and validate sterilization regimes for Bacillus subtilis spores in an experiment using supercritical carbon dioxide (scCO2), including pure scCO2, scCO2 with hydrogen peroxide, and scCO2 with peracetic acid.
MATERIALS AND METHODS
Experimental facility
The experiments were conducted using a prototype test bench for studying sterilization regimes (Skolkovo Institute of Science and Technology, Russia). The facility included a 1 L working chamber made of AISI 316 stainless steel, with temperature control from ambient to 100°C and a maximum working pressure of 120 atm. The system was equipped with a programmable logic controller (PLC) for automatic cycle control, redundant pressure monitoring (analog pressure gauges and digital sensors), and a PID temperature controller (TPM210). Medical-grade CO2 was used as the sterilizing agent. Figure 1 presents a general schematic description of this facility.

Figure prepared by the authors based on their own data
Fig. 1. Pneumatic schematic of the prototype test bench for investigating sterilization regimes: 1 — gas cylinder; 2 — first valve; 3 — filter; 4 — pump; 5 — safety valve; 6 — first control valve; 7 — working chamber; 8 — throttle valve; 9 — second control valve; 10 — electronic pressure gauge; 11 — temperature sensor; 12 — second valve
Biological Indicator
The microorganism Bacillus subtilis subsp. Spizizenii ATCC 6633 NCTC 10400 was used as the biological indicator.
Culture preparation and sample contamination
Nutrient agar medium No. 1 GRM of the following composition was used for cultivation: casein hydrolysate (5.00 g/L); yeast extract (2.50 g/L); glucose (1.00 g/L); and agar-agar (9.00 g/L). Inoculations were incubated at a temperature of 37.1°C for 24 h.
The inoculum was prepared from a 24-h agar culture by selecting well-isolated colonies and transferring them into a sterile 0.9% sodium chloride (NaCl) solution to a concentration equivalent to 0.5 McFarland standard units [11]. The suspension density was controlled using a DEN-1 densitometer (Biosan, Latvia). The inoculum was used within 15 min of preparation.
A volume of 100 µL of the inoculum was applied onto the surface of titanium discs using an automatic micropipette and dried to completeness at a temperature of 20 ± 2°C under sterile conditions. The contaminated discs were packaged in individual kraft paper bags prior to gas-dynamic treatment (Fig. 2A).

Figure prepared by the authors based on their own data
Fig. 2. Preparation of titanium discs for gas-dynamic treatment: A — individual packaging of a contaminated titanium disc in a kraft paper bag; B — placement of the packaged disc in a test tube with oxidizer solution for treatment according to CDHP or CDPAA protocols
Microbiological analysis
Following sterilization, the samples were removed from the kraft bags and placed into sterile containers with 5 mL of 0.9% sodium chloride (NaCl) solution. The wash-off was performed by shaking for 1.5 min at 1000 rpm using a V-3 vortex mixer.
The wash fluid was plated in a volume of 200 µL (for screening experiments) or 1000 µL (for validation experiments with SAL calculation) onto the surface of nutrient agar in 90 mm Petri dishes. The difference in plating volumes is related to methodological requirements. Thus, for screening experiments, a 200 µL volume provided sufficient sensitivity while reducing the load on the automatic counting system Scan 500; for validation experiments, the 1000 µL volume maximized the sensitivity of the analysis in accordance with GOST R ISO1. The fluid was evenly distributed over the surface of the medium using a sterile Drigalski spatula. The inoculations were incubated at 37°C for 24 h.
The results were recorded both visually and using a Scan 500 automatic colony counter (Interscience, France). For plates with confluent growth, counting was performed automatically using a Scan 500 system via the selected field method. The latter consisted in defining the counting area followed by calculation of the colony density and its automatic recalculation for the entire plate area, converted to CFU/mL while accounting for the inoculation volume. Reference samples were not subjected to sterilization; the wash-off from these controls was performed immediately after contamination using the same method. The minimum detectable number of viable microorganisms (limit of detection, LOD) was 1 CFU/mL.
Preparation of chemical additives
Solutions of hydrogen peroxide (H2O2) and peracetic acid (C2H4O3) were prepared under controlled conditions as part of a scientific collaboration with the Mendeleev Russian University of Chemical Technology. The solutions were prepared using Type I ultrapure water, obtained through double reverse osmosis and UV treatment. All preparation and dispensing procedures were carried out in a glove box under inert atmosphere.
The working concentrations were 200 ppm (0.02%) for hydrogen peroxide and 50 ppm (0.005%) for peracetic acid.
The solutions were prepared in batches, considering a shelf life of up to one week under storage conditions recommended by the Mendeleev University (at low temperature, protected from light). The incoming quality control of the stock solutions was performed using redox titration methods to verify their concentration.
Experimental design
Using the Minitab 17.1 statistical software, three separate Central Composite Designs (CCD) were generated, one for each treatment group: CD (pure carbon dioxide), CDHP (carbon dioxide + hydrogen peroxide), and CDPAA (carbon dioxide + peracetic acid).
For the CD group, temperature (35–60°C), pressure (70–120 atm), and exposure duration (60–120 min) were varied within a single block, based on literature data [5][7][8] and considering the engineering constraints of the equipment (Pmax = 120 atm).
The CDHP and CDPAA groups were investigated at temperatures of 30–45°C, pressures of 90–110 atm, and exposure duration of 10–30 min, according to data from [9][12], with the experiments organized into three blocks.
Each Central Composite Design (CCD) included 20 experimental runs: 8 cube points, 6 axial points, and center points with α = 1. All equipment operations were performed by a single operator, while all microbiological procedures were conducted by one microbiologist to ensure data homogeneity.
The validation of optimal sterilization regimes involved conducting a series of 10 independent replicates for each regime, followed by the calculation of the log-reduction relative to the control (N0). When more than two models and corresponding optimal regimes were identified, a comparative analysis of the log-reduction values between the groups was planned for the statistical assessment of differences in sterilization efficacy.
The experimental runs were performed according to the CCD matrix, with process parameter deviations controlled within ± 2°C for temperature, ± 5 atm for pressure, and ± 2 min for exposure time.
Experimental procedure
Each experiment involved the preparation of two samples (on a matrix of titanium discs measuring 8 × 1 mm): a reference and a test (experimental) sample. The test samples for the CD regime were packaged in kraft paper (Fig. 2A). For the CDHP and CDPAA regimes, they were additionally fully immersed in 15 mL of the corresponding additive solution in open test tubes placed inside the reaction chamber (Fig. 2B).
The experimental procedure involved sample preparation and loading into the working chamber, followed by sealing and achieving the specified CO2 temperature and pressure conditions. After maintaining the target conditions for the designated exposure time, a controlled decompression (≤ 10 atm/min to minimize mechanical inactivation effects) was performed, followed by sample retrieval and microbiological analysis.
The process parameters (temperature, pressure, duration) were monitored manually using redundant analog and digital sensors. Experiments were conducted at an ambient temperature of 20–25°C and a relative humidity of 50 ± 10%.
Statistical analysis
The logarithmic reduction (log-reduction), calculated using formula (1), was used as the response variable:
(1)
where N0 — the number of viable microorganisms in the reference sample; N — after treatment.
To identify the dependence of sterilization efficacy on process parameters, the response surface methodology (RSM) with the construction of full quadratic models was applied.
For each experimental group, a preliminary assessment of data distribution using the Anderson–Darling (AD) test was planned. Depending on the outcome of the normality test, either a two-sample t-test (in the absence of significant deviations) or a non-parametric Mann–Whitney U test (MW), corrected for ties, was planned for comparing reference and test samples. The sterility of medical devices was considered achieved at a log-reduction ≥ 6, which corresponds to a Sterility Assurance Level (SAL) of ≤ 10⁻⁶ according to GOST requirements2.
RESULTS
Results for the CD Group
Raw data and response distribution. In the experiment on the treatment of Bacillus subtilis spores with pure CO2, 20 runs were conducted, varying temperature (35–60°C), pressure (70–120 atm), and exposure duration (60–120 min). The mean log-reduction was 0.52 ± 0.35 (AD: p > 0.05).
DOE Analysis: Full Quadratic Model. An analysis of variance (ANOVA) indicated the lack of statistical significance for the model (F = 0.26; p = 0.972; R² = 19.1%, adj R² = 0%). Only 19% of the variability can be explained by the process factors (temperature, pressure, exposure duration), while the remaining 81% is attributed to random error. None of the coefficients, including main, quadratic, and interaction terms, were statistically significant (all p > 0.2).
With the purpose of verifying the robustness of the conclusion regarding the statistical insignificance of the full quadratic model, a stepwise variable elimination procedure (backward elimination method) was additionally applied at α = [ 0.1; 0.3] (step = 0.1). In all cases, the final model was reduced to a constant, since no variable reached statistical significance (minimum p = 0.24), and the explained variance did not exceed 10%.
Statistical analysis of differences between groups
In the control group CD (N0), the median number of viable spores was 4.34 × 10³ [ 2940; 5245] CFU/mL, compared to 1.57 × 10³ [ 556; 2678] CFU/mL in the treated CD group (N).
A test for normality of the data distribution showed no deviations from a normal distribution in the treated group (AD: p > 0.05). However, a statistically significant deviation was detected in the control group (AD: p < 0.05). Consequently, a non-parametric test was applied for intergroup comparison, which revealed a statistically significant difference (MW: p < 0.001). Thus, the reduction in the number of viable spores after treatment with pure CO2 was established to be statistically significant.
Results for the CDHP group
Raw data and the dynamics of experimental series expansion. In the initial series of experiments on treating Bacillus subtilis spores with a mixture of CO2 and hydrogen peroxide (CDHP), 20 runs were performed, varying temperature (30–45°C), pressure (90–110 atm), and exposure duration (10–30 min). An analysis of the constructed regression model revealed a low explained variance (R² = 45%; adj R² = 0%). All coefficients, including linear, quadratic, and interaction effects, were statistically insignificant (p > 0.4), and the lack-of-fit test showed a high p-value (p = 0.94), indicating the inability of the model to explain the variation in the experimental data. A stepwise factor elimination procedure (backward elimination method) failed to select any predictors, and the final model included only a constant.
Given that the structure of the initial experimental design was unbalanced—the majority of replicates were concentrated at the center point (seven replicates), while only two experiments were performed at the extreme factor levels (pressure of 90 and 110 atm; exposure duration of 10 and 30 min), and independent replicates were missing for several factor combinations — these results collectively indicated insufficient informativeness of the initial design and justified the need for targeted expansion of the series.
Consequently, five points were added, located in the central region and at the boundaries of the varying factors (Table 3, No. 21–25). In the expanded sample (n = 25), a slight improvement in model parameters was observed (R² = 40%; adj R² = 4%); however, key effects remained insignificant (p > 0.25 for all factors; lack-of-fit: p = 0.97), and the stepwise elimination procedure again failed to identify statistically significant predictors. To further investigate the influence of pressure on sterilization efficacy, six points with extreme pressure values (70 and 120 atm, at a fixed temperature of 38°C) were added. The median log-reduction for the full sample (n = 31) was 1.31 [0.50; 2.61] (AD: p < 0.05).
Figure prepared by the authors based on original data
Fig. 3. Example of Petri dish appearance: reference sample (left) and sample after treatment using one of the studied CDHP regimes (right)
Final analysis of the experimental series (n = 31): Model and statistical parameters
In order to determine the influence of factors on spore inactivation efficacy, a multiple regression model was constructed using a stepwise backward elimination procedure (α = 0.1). The final model included the linear and quadratic effects of temperature and pressure, as well as the linear effect of exposure duration. Interaction effects between factors were excluded as non-significant. The regression equation for the predicted log-reduction value for the CDHP group (YCDHP) is as follows:
YCDHP = 1.60 + 0.387 × tC – 0.1800 × Patm +
+ 0.01542 × Tmin – 0.00511 × tC² + 0.000996 × Patm². (2)
The explanatory power of the model increased to 58.5% (R² = 58.5%; adj R² = 50.2%; pred R² = 38.5%; lack-of-fit: p = 0.32). The quadratic terms for temperature (p < 0.05) and pressure (p < 0.001), as well as the linear effect of pressure (p < 0.05), were found to be statistically significant, while all other variables were excluded during the selection process due to a lack of significance (p > 0.1).
Statistical analysis of differences between groups
In the CDHP control group (N0, n = 31), the median number of viable spores was 3.1 × 10³ [ 2950; 3680] CFU/mL, compared to 1.9 × 10² [ 101; 474] CFU/mL in the treated group (N, n = 31). Testing for normality in the distribution of CFU/mL revealed statistically significant deviations from a normal distribution in both groups (AD: p < 0.005). In this light, a non-parametric test was applied for intergroup comparison, the results of which showed a statistically significant difference between the groups (MW: p < 0.0001). The treatment effect is clearly demonstrated by the appearance of the reference and treated samples (Fig. 3).
Search for optimal processing conditions
In order to determine optimal sterilization regimes, an analysis of the obtained regression model (YCDHP) was performed. The maximum value of the log-reduction within the range of the investigated factors was used as the optimality criterion (Fig. 4).

Figure prepared by the authors based on original data
Fig. 4. Response surfaces of the log-reduction parameter based on the regression model for the CDHP group (n = 31): A — P_atm and t_C at fixed T (30 min); B — P_atm and T_min at fixed t (37.9°C); C — t_C and T_min at fixed P (120 atm); t_C — temperature; P_atm — pressure, atm; T_min — exposure time, min; log_red — response (log10-reduction, log10 units)
The calculation results were used to determine that the maximum effect is achieved at a temperature of 37.9°C, a pressure of 120 atm, and an exposure duration of 30 min (Fig. 5). Under these conditions, the predicted log-reduction value is 2.14 (95% CI: [ 1.78; 2.50]; 95% PI (prediction interval): [ 1.42; 2.87]), and the integral optimality criterion (D) for the identified solution is 0.78.

Figure prepared by the authors based on original data
Fig. 5. Graph of the search for optimal processing conditions for the CDHP group: n = 31; t_C — temperature, °C; P_atm — pressure, atm; T_min — exposure time, min; log_red — log10 reduction; D — composite desirability; vertical lines — optimal factor levels
Model diagnostics
Diagnostics of the final regression model (n = 31) was performed based on visual analysis of residual distribution. The normal probability plot (Fig. 6A) revealed a deviation of residuals from the normal distribution; however, no explicit outliers or structural patterns were detected. Similarly, the plot of residuals versus predicted values (Fig. 6B) showed no systematic trends or signs of heteroscedasticity.

Figure prepared by the authors based on original data
Fig. 6. Diagnostics of the log-reduction model residuals (CDHP group, n = 31): A — normal probability plot (X-axis: residuals, log10 units; Y-axis: percentage, %); B — residuals vs. predicted values plot (X-axis: predicted log10 reduction values; Y-axis: residuals, log10 units)
Results for the CDPAA group
Original data and response distribution. In the experiment on the treatment of B. subtilis spores with a mixture of CO2 and peracetic acid (CDPAA), 20 runs were conducted with variations in temperature (30–45°C), pressure (90–110 atm), and exposure duration (10–30 min). The mean log-reduction was 2.10 ± 0.90 (AD: p > 0.05).
DOE analysis: Full quadratic model
Unlike previous experimental series, it was decided for the CDPAA regime not to simplify the full quadratic model, since its quality metrics were deemed satisfactory (R² = 78.0%; adj R² = 47.6%; lack-of-fit: p = 0.08). The regression equation for the predicted log-reduction value for the CDPAA group (YCDPAA) takes the following form:
YCDPAA = –19,80 + 0,163 × tC + 0,387 × Patm –
– 0,106 × Tmin – 0,00219 × tC² – 0,00263 × Patm² +
+ 0,00027 × tmin² + 0,00190 × tC × Patm – (3)
– 0,00347 × tC × Tmin + 0,00207 × Patm × Tmin.
Of all the factors included in the model, only the linear effect of temperature was statistically significant (p < 0.05), whereas the effects of pressure (p > 0.05), exposure duration (p > 0.05), and the quadratic and interaction terms did not reach statistical significance (all p > 0.22).
Statistical analysis of intergroup differences
In the CDPAA control group (N0, n = 20), the median number of viable spores was 2.13 × 10³ [ 1600; 3973] CFU/mL, compared to 2.21 × 10¹ [ 12.5; 41.1] CFU/mL (AD: p < 0.005) in the experimental group (N, n = 20). Statistical analysis of significance of differences confirmed a significant reduction in viable spores after treatment (MW: p < 0.0001). Figure 7 shows a comparison of the appearance of the reference and test samples.
Figure prepared by the authors based on original data
Fig. 7. Example of Petri dish appearance: reference sample (left) and sample after treatment with one of the studied CDPAA regimes (right)
Optimization of treatment conditions
The full quadratic model YCDPAA (Fig. 8) was used to determine optimal sterilization regimes based on the criterion of log-reduction maximization.

Figure prepared by the authors based on original data
Fig. 8. Response surface of the log-reduction parameter according to the regression model for the CDPAA group: A — P_atm and t_°C at fixed T (10 min); B — P_atm and T_min at fixed t (45°C); C — t_°C and T_min at fixed P (94 atm); t_°C — temperature, °C; P_atm — pressure, atm; T_min — exposure duration, min; log_red — response: log10-reduction (log10 units)
According to the optimization results, the highest predicted log-reduction value is 3.60 (95% CI: [ 2.37; 4.82]; 95% PI: [ 1.65; 5.54]), achieved at a temperature of 45°C, pressure of 94 atm, and exposure duration of 10 min. For these conditions, the composite desirability of the model equals 0.95 (D), indicating a high degree of conformity between the selected regime and the specified parameters (Fig. 9).

Figure prepared by the authors based on original data
Fig. 9. Optimization plot of treatment conditions for the CDPAA group: t_°C — temperature, °C; P_atm — pressure, atm; T_min — exposure duration, min; log_red — log10-reduction; D — composite desirability; vertical lines — optimal factor levels
Model diagnostics
Evaluation of the normal probability plot of residuals (Fig. 10A) and the plot of residuals versus predicted values (Fig. 10B) revealed no deviations from normal distribution or signs of heteroscedasticity.

Figure prepared by the authors based on original data
Fig. 10. Residuals diagnostics for the log-reduction model (CDPAA group): A — normal probability plot (X-axis: residuals, log10 units; Y-axis: percentage, %); B — residuals vs. predicted values plot (X-axis: predicted log10-reduction values, log10 units; Y-axis: residuals, log10 units)
Validation of optimal sterilization regimes
In order to confirm the effectiveness of the established optimal sterilization conditions and evaluate the method reproducibility, validation experiments with ten independent replicates for each regime were conducted. In the CDHP regime (37.9°C, 120 atm, 30 min, 200 ppm H2O2), the mean log-reduction was 4.4 ± 0.3 with a coefficient of variation of 7.3%. For the CDPAA regime (45°C, 94 atm, 10 min, 50 ppm PAA), the mean log-reduction was 6.0 ± 0.3, with a coefficient of variation of 4.9%. In all experiments, the log-reduction values exceeded the detection limit of the method (1 CFU/mL).
The data distribution in both groups conformed to the normal distribution (AD: p > 0.05), allowing the use of a t-test to compare the effectiveness of the regimes. It was found that the CDPAA regime enables a statistically significant higher spore inactivation compared to CDHP (mean difference 1.60 (log-reduction); 95% CI: [ 1.31; 1.89]; p < 0.001).
DISCUSSION
Our comparative evaluation of the sterilizing effect of supercritical CO2 and its combinations with oxidizing agents on B. subtilis spores found that the use of CO2 alone (CD regime) did not lead to a significant reduction in the spore viability: in all tested parameter combinations, the inactivation level did not exceed 0.8 log orders. The introduction of oxidizing agents — hydrogen peroxide (CDHP) and peracetic acid (CDPAA) — yielded fundamentally different results. According to validation series data, for the CDHP regime, the mean reduction was 4.42 ± 0.32 log orders (CV = 7.30%) at 37.9°C, 120 atm, 30 min, compared to 6.02 ± 0.30 log orders (CV = 4.98%) at 45°C, 94 atm, 10 min, for CDPAA.
The coefficients of variation were calculated from a series of 10 independent replicates for regimes with oxidizing agents; for the CD regime, separate validation experiments were not conducted since no optimal conditions providing a high degree of inactivation could be identified.
The four-fold or greater reduction of viable B. subtilis spores achieved in our study through treatment with scCO2 and hydrogen peroxide indicates the potential of this approach for high-level disinfection of semi-critical medical devices [1][13]. Such an inactivation level is considered acceptable in current international guidelines for ensuring the microbiological safety of devices where absolute sterility is not required but effective protection against most pathogens is necessary [13–15]. It should be emphasized that we primarily assessed spore inactivation; therefore, further analysis of antimicrobial activity against other clinically relevant microorganisms is required for practical implementation of the method.
The low effectiveness of Bacillus subtilis spore sterilization using pure CO2, observed across the studied range of temperatures (35–60°C), pressures (70–120 atm), and exposure duration (1–2 h), is fully consistent with the results of several independent studies. In the work by Spilimbergo et al. [5] at 36°C, 80 atm, and extended exposure (up to 48 h), the log-reduction for B. subtilis spores was 0.5–0.9, which agrees with our values of 0.4–0.8 at significantly shorter treatment modes. Dillow et al. [16] demonstrated that at 205 bar (~200 atm), 34°C, and a 2-h exposure, the log-reduction for Bacillus cereus spores did not exceed 1–2 units. Only at 60°C with an increased duration of 4 h, a log-reduction of 5–8 units was achieved, which falls outside the scope of most regimes applicable to medical devices. White et al. [17] confirmed that even at 96–103 atm and 35–60°C following a 72-h exposure, the log-reduction for B. subtilis and B. stearothermophilus spores remained close to zero; significant inactivation was observed only upon the addition of oxidizers or water.
Altogether, these data confirms that spore sterilization using pure CO2 is ineffective under mild and moderate regimes. In practice, such inactivation requires either an extreme increase in temperature or a significant extension of treatment exposure, which is often impractical or economically unfeasible when working with medical materials. In our study, the parameter range was selected based on the constraints of the experimental facility and the objectives related to the applicability of the method for processing medical devices, which aligns with real-world production conditions and the prospects for subsequent technology implementation.
The agreement between our obtained log-reduction values and the ranges reported in several independent studies for Bacillus spp. spores under similar conditions [5][16][17] may indicate a certain reproducibility of the low effectiveness of pure CO2 within the studied regimes. Despite differences in experimental models, subjects, and protocol details, no significant discrepancies in the achieved level of inactivation were observed. However, definite conclusions regarding reproducibility require specifically designed interlaboratory studies with control of critical parameters.
It should be noted that we were unable to identify other publications on the use of the B. subtilis strain and comparable treatment conditions (200 ppm H2O2, temperature, pressure), except for the work by Warambourg et al. [6], whose parameters were used as a reference when planning our experiments. In our study, the optimal process parameters (120 bar, 37.9°C, 30 min, 200 ppm H2O2) differed from those described by Warambourg et al. [6] (110 bar, 40°C, 20 min, 200 ppm H2O2), although being close in values. The overlap in the ranges of optimal conditions, determined independently, may be considered an indication of partial reproducibility of the “optimal sterilization window” for scCO2 with H2O2 for B. subtilis. However, the achieved log-reduction values differed significantly (4.42 vs. 8.73), indicating limitations in quantitative reproducibility between different laboratories and underscoring the importance of standardizing experimental methods and reference materials.
Regarding the application of CDPAA, the most similar conditions to the present study are found in the experiments by Setlow et al., where for B. subtilis at 35–55 ppm PAA, 35°C, 100 bar, and an exposure duration of 25 min, a reduction in viability of more than 6 log orders was observed [12]. In our study, the optimal parameters were 45°C, 94 bar, 10 min, 50 ppm PAA. Thus, while the ranges of concentration, pressure, and temperature that result in significant inactivation were similar, differences in exposure duration and protocol details preclude claims of reproducibility in the strict sense and complicate a direct quantitative comparison of effectiveness.
Despite the partial overlap of key parameters with those used in publications, a correct quantitative comparison of inactivation effectiveness remains challenging. The main reasons stem from differences in the specific strains used, the geometry and material of the substrate, the method and volume of inoculum application, the recovery procedure, as well as details of the experimental protocols. This variability underscores the need for further standardization and interlaboratory alignment of key parameters in scCO2 sterilization research.
The available literature data on spore inactivation using scCO2 in combination with oxidizing agents (hydrogen peroxide, peracetic acid) are highly heterogeneous. Most publications investigate different Bacillus strains (most commonly B. atrophaeus, B. pumilus, G. stearothermophilus), employ substantially different oxidizer concentrations, and utilize varied experimental protocols [18]. We were unable to identify any studies that simultaneously used low oxidizer concentrations, conditions comparable to the present study in terms of temperature and pressure, and B. subtilis as the test organism. This fragmentation and lack of standardization hinder a correct quantitative comparison of inactivation effectiveness between the results of the present work and most published data. The necessity for further research using identical biological materials and harmonized regimes is emphasized in a number of recent reviews [12][18].
Our analysis of the contribution of individual factors revealed that in the CDHP regime, pressure exerted a highly significant influence both in linear (p < 0.05) and quadratic (p < 0.001) terms, with the quadratic effect being the most pronounced. In the CDPAA regime, the linear effect of pressure did not reach statistical significance (p > 0.226), which is likely associated not only with differences in the chemical properties of the oxidizing agents but also with characteristics of the matrix and the local availability of the sterilizing agent [9]. Our data are partially consistent with those of Hossain et al., where pressure was the determining factor for bacterial inactivation under pure scCO2 treatment conditions; however, that study primarily investigated vegetative forms rather than spores [8]. According to Zhang et al., pressure enhances the solubility and penetration of CO2 through cellular barriers, although the efficiency of this process can vary significantly for spores [7][9].
Temperature demonstrated consistent significance in both models: for CDHP — as both a linear (p < 0.01) and quadratic (p < 0.05) effect; for CDPAA — as the dominant linear factor (p < 0.05). This highlights the leading role of temperature when oxidizers are added to overcome spore barriers. The significance of the temperature factor identified in our study for the regime with peracetic acid aligns with the data by Zhang et al., according to whom an increase in temperature enhances CO2 diffusion and the fluidity of cellular structures [7].
Exposure duration was statistically significant only for CDHP (p < 0.05) but not for CDPAA (p > 0.407), which is also consistent with literature data indicating a relatively smaller contribution of exposure duration compared to pressure and temperature [7][9]. The faster action of peracetic acid may explain the reduced dependence on exposure duration.
The pressure–temperature interaction was statistically significant for both regimes (CDHP: p < 0.05; CDPAA: p < 0.05), indicating a synergistic effect between these parameters. It appears that at pressures above the critical point for CO2, diffusion is primarily governed by pressure, while increasing temperature further enhances membrane fluidity and activates oxidative processes [7][8].
In our study, rapid decompression after treatment was intentionally excluded to minimize the contribution of mechanical damage to spores and to obtain a more objective assessment of the chemical action of scCO2 and oxidizing agents. This approach is justified by the results of several studies demonstrating that rapid decompression can have a significant effect on inactivation through physical effects unrelated to the action of the agent itself [5][7][8]. In our opinion, this approach provides more reliable data on inactivation mechanisms.
The validation experiments showed log-reduction values substantially exceeding the upper bounds of the prediction intervals calculated from the main series during the optimization of the regimes. This discrepancy is attributed not only to the application of the optimized regimes but also to the use of different microbiological approaches in the two series. Thus, during model construction, the initial spore concentration was lower (to ensure stable operation of the automatic counter), whereas validation was performed at the normative load (N0 ≥ 10⁶) required for SAL calculation [14][15].
Our study is not devoid of several limitations that should be considered when interpreting and practically applying the data obtained. The work was conducted on a single laboratory facility with a maximum pressure of 120 atm, which limits the range of investigated regimes. The experiments were performed with only one model organism (Bacillus subtilis subsp. spizizenii ATCC 6633) and on titanium discs. Therefore, the effectiveness of the method when applied to other microorganisms and materials was not evaluated. The result reproducibility was determined only within a single laboratory setting, without interlaboratory comparisons. In addition, we did not investigate the effect of sterilization on the functional properties and biocompatibility of medical devices. All these limitations should be considered when planning further work and translating laboratory results into practice.
CONCLUSIONS
During the conducted experimental studies using supercritical carbon dioxide (scCO2), including pure scCO2, scCO2 with hydrogen peroxide (H2O2), and scCO2 with peracetic acid (PAA), regimes for the inactivation of Bacillus subtilis spores on titanium discs were validated. Optimal conditions for the low-temperature processing of thermally sensitive medical materials, compliant with modern international requirements, were experimentally substantiated. The scCO2 with peracetic acid regime achieves a sterility assurance level (SAL) of ≤ 10⁻⁶, which is required for the sterilization of medical devices. The scCO2 with hydrogen peroxide regime exceeds SAL ≤ 10⁻⁴, corresponding to high-level disinfection. The use of pure scCO2 alone proved insufficiently effective (maximum 0.8 log-reduction).
Authors’ contributions. All authors confirm that their authorship meets the ICMJE criteria. The primary contributions are distributed as follows: Ramaz Sh. Gvetadze — administrative management of the project, manuscript review and editing; Mariam S. Galstyan — conducting experiments on the facility, processing primary data, writing the initial version of the article, and preparing illustrative material; Yaser N Kharakh — developing the statistical design of the study, statistical analysis, and results interpretation; Petr Yu. Kolesnikov — conducting microbiological research, cultivating microorganisms, and performing microbiological analysis; Levon G. Kirakosyan — technical support for experiments, conducting validation experiments, and writing the methodology and results sections; Mikhail S. Podporin — planning experiments to optimize modes, and scientific and methodological support; Viktor N. Tsarev — concept of the microbiological part of the study, provision of laboratory resources, and scientific editing; Sergey D. Arutyunov — study conceptualization, methodology development, and approval of the final version of the manuscript for publication.
1. GOST R ISO 14937-2012 (ISO 14937:2009). Sterilization of health care products. General requirements for characterization of a sterilizing agent and the development, validation and routine control of a sterilization process for medical devices. Moscow: Standartinform; 2013.
2. GOST R ISO 14937-2012 (ISO 14937:2009). Sterilization of health care products. General requirements for characterization of a sterilizing agent and the development, validation and routine control of a sterilization process for medical devices. Moscow: Standartinform; 2013.
References
1. Rowan NJ, Kremer T, McDonnell G. A review of Spaulding’s classification system for effective cleaning, disinfection and sterilization of reusable medical devices: viewed through a modern-day lens that will inform and enable future sustainability. Science of the Total Environment. 2023;878:162976. https://doi.org/10.1016/j.scitotenv.2023.162976
2. Spaulding AB, Watson D, Dreyfus J, Heaton P, Grapentine S, Bendel-Stenzel E, et al. Epidemiology of bloodstream infections in hospitalized children in the United States, 2009– 2016. Clinical Infect Diseases. 2019;69(6):995–1002. https://doi.org/10.1093/cid/ciy1030
3. Stewart S, Robertson C, Pan J, Kennedy S, Dancer S, Haahr L, et al. Epidemiology of healthcare-associated infection reported from a hospital-wide incidence study: considerations for infection prevention and control planning. Journal of Hospital Infection Society. 2021;114:10–22. https://doi.org/10.1016/j.jhin.2021.03.031
4. Arutyunov SD, Yanushevich OO, Korsunsky AM, Podporin MS, Salimon AI, Romanenko II, et al. Comparative analysis of the effectiveness of modern methods of sterilization of instruments and the place of gas-dynamic treatment with carbon dioxide. Russian Journal of Stomatology. 2022;15(1):12–9 (In Russ.). https://doi.org/10.17116/rosstomat20221501112
5. Spilimbergo S, Bertucco A, Lauro FM, Bertoloni G. Inactivation of Bacillus subtilis spores by supercritical CO<sub>2</sub> treatment. Innovative Food Science and Emerging Technologies. 2003;4(2):161–5. https://doi.org/10.1016/S1466-8564(02)00089-9
6. Warambourg V, Mouahid A, Crampon C, Galinier A, Claeys-Bruno M, Badens E. Supercritical CO<sub>2</sub> sterilization under low temperature and pressure conditions. The Journal of Supercritical Fluids. 2023;203:106084. https://doi.org/10.1016/j.supflu.2023.106084
7. Zhang J, Davis TA, Matthews MA, Drews MJ, LaBerge M, An YH. Sterilization using high-pressure carbon dioxide. The Journal of Supercritical Fluids. 2006;38(3):354–72. https://doi.org/10.1016/j.supflu.2005.05.005
8. Hossain MS, Nik Ab Rahman NN, Balakrishnan V, Alkarkhi AFM, Rajion ZA, Ab Kadir MO. Optimizing supercritical carbon dioxide in the inactivation of bacteria in clinical solid waste by using response surface methodology. Waste Management. 2015;43:402–9. https://doi.org/10.1016/j.wasman.2015.01.003
9. Qiu QQ, Leamy P, Brittingham J, Pomerleau J, Kabaria N, Connor J. Inactivation of bacterial spores and viruses in biological material using supercritical carbon dioxide with sterilant. Journal of Biomedical Materials Research B Applied Biomaterials. 2009;91B(2):572–8. https://doi.org/10.1002/jbm.b.31431
10. Salimon AI, Statnik ES, Kan Y, Yanushevich OO, Tsarev VN, Podporin MS, et al. Comparative study of biomaterial surface modification due to subcritical CO<sub>2</sub> and autoclave disinfection treatments. The Journal of Supercritical Fluids. 2022;191:105789. https://doi.org/10.1016/j.supflu.2022.105789
11. McFarland J. The nephelometer: an instrument for estimating the number of bacteria in suspensions used for calculating the opsonic index and for vaccines. JAMA. 1907;49(14):1176–8. https://doi.org/10.1001/jama.1907.25320140022001f
12. Setlow B, Korza G, Blatt KMS, Fey JP, Setlow P. Mechanism of Bacillus subtilis spore inactivation by and resistance to supercritical CO<sub>2</sub> plus peracetic acid. Journal of Applied Microbiology. 2016;120(1):57–69. https://doi.org/10.1111/jam.12995
13. von Woedtke T, Kramer A. The limits of sterility assurance. GMS Krankenhhyg Interdiszip. 2008;3(3):Doc19.
14. Rutala WA, Weber DJ. Sterilization, high-level disinfection, and environmental cleaning. Infectious Disease Clinics of North America. 2011;25(1):45–76. https://doi.org/10.1016/j.idc.2010.11.009
15. Shenoy ES, Weber DJ, McMullen K, Rubin Z, Sampathkumar P, Schaffzin JK, et al. Multisociety guidance for sterilization and high-level disinfection. Infection Control Hospital Epidemiology. 2025. https://doi.org/10.1017/ice.2025.41
16. Dillow AK, Dehghani F, Hrkach JS, Foster NR, Langer R. Bacterial inactivation by using near- and supercritical carbon dioxide. PNAS. 1999;96(18):10344–8. https://doi.org/10.1073/pnas.96.18.10344
17. White A, Burns D, Christensen TW. Effective terminal sterilization using supercritical carbon dioxide. Journal of Biotechnology. 2006;123(4):504–15. https://doi.org/10.1016/j.jbiotec.2005.12.033
18. Soares GC, Learmonth DA, Vallejo MC, Davila SP, González P, Sousa RA, et al. Supercritical CO<sub>2</sub> technology: The next standard sterilization technique? Material Science and Engineering: C. 2019;99:520–40. https://doi.org/10.1016/j.msec.2019.01.121
About the Authors
R. Sh. GvetadzeRussian Federation
Ramaz Sh. Gvetadze, Dr. Sci. (Med.), Professor, Academician of RAS
Moscow
M. S. Galstyan
Russian Federation
Mariam S. Galstyan
Moscow
Ya. N. Kharakh
Russian Federation
Yaser N. Kharakh, Cand. Sci. (Med.)
Moscow
P. Yu. Kolesnikov
Russian Federation
Petr Yu. Kolesnikov
Moscow
L. G. Kirakosyan
Russian Federation
Levon G. Kirakosyan, Cand. Sci. (Med.)
Moscow
M. S. Podporin
Russian Federation
Mikhail S. Podporin, Cand. Sci. (Med.)
Moscow
V. N. Tsarev
Russian Federation
Viktor N. Tsarev, Dr. Sci. (Med.), Professor
Moscow
S. D. Arutyunov
Russian Federation
Sergey D. Arutyunov, Dr. Sci. (Med.), Professor
Moscow
Review
For citations:
Gvetadze R.Sh., Galstyan M.S., Kharakh Ya.N., Kolesnikov P.Yu., Kirakosyan L.G., Podporin M.S., Tsarev V.N., Arutyunov S.D. Optimization and validation of Bacillus subtilis spore inactivation regimes in supercritical carbon dioxide: Pure gas, hydrogen peroxide, peracetic acid. Extreme Medicine. 2026;28(1):134-145. https://doi.org/10.47183/mes.2025-359
JATS XML








